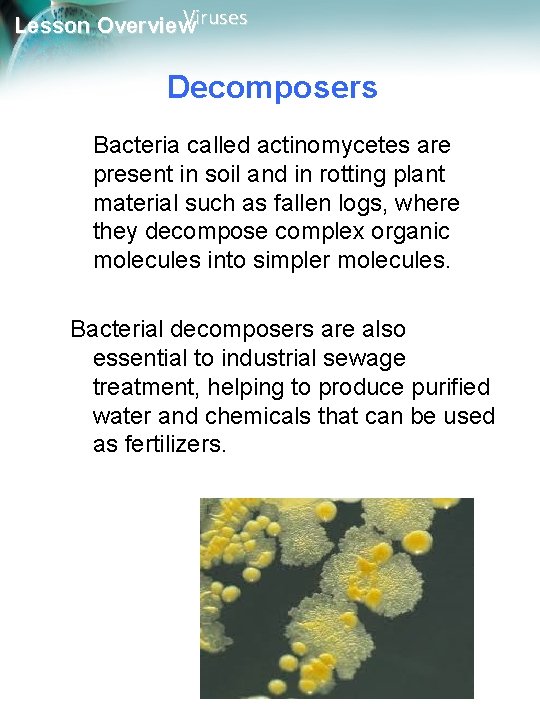
Viruses Lesson Overview Decomposers Bacteria called actinomycetes are present in soil and in rotting

Viruses Lesson Overview 20 2 Prokaryotes Viruses Lesson

- Slides: 15
Viruses Lesson Overview 20. 2 Prokaryotes
Viruses Lesson Overview Classifying Prokaryotes are divided into two very distinct groups: Bacteria and Archaea. These groups are very different from each other; therefore, biologists now consider each group of prokaryotes as a separate domain. Eukaryotes are third domain.
Viruses Lesson Overview Bacteria The larger of the two domains of prokaryotes is the Bacteria live almost everywhere— fresh water, salt water, on land, on and within bodies of humans and other eukaryotes. Escherichia coli, a typical bacterium that lives in human intestines, is shown.
Viruses Lesson Overview Bacteria are usually surrounded by a cell wall. Some bacteria, such as E. coli, have a second membrane outside the peptidoglycan wall that makes the cell especially resistant. In addition, some prokaryotes have flagella that they use for movement, or pili, which in E. coli serve mainly to anchor the bacterium to a surface or to other bacteria.
Viruses Lesson Overview Archaea Under a microscope, archaea look very similar to bacteria. Both are equally small, lack nuclei, and have cell walls, but there are important differences. The walls of archaea lack peptidoglycan, and their membranes contain different lipids. The DNA sequences of key archaea genes are more like those of eukaryotes than those of bacteria. Based on these observations, scientists have concluded that archaea and eukaryotes are related more closely to each other than to bacteria.
Viruses Lesson Overview Archaea Many archaea live in extremely harsh environments. One group of archaea produce methane gas and live in environments with little or no oxygen, such as thick mud and the digestive tracts of animals. Other archaea live in extremely salty environments, such as Utah’s Great Salt Lake, or in hot springs where temperatures approach the boiling point of water.
Viruses Lesson Overview Size, Shape, and Movement Prokaryotes range in size from 1 to 5 micrometers, making them much smaller than most eukaryotic cells. Prokaryotes come in a variety of shapes. Rod-shaped prokaryotes are called bacilli. Spherical prokaryotes are called cocci. Spiral and corkscrew-shaped prokaryotes are called spirilla. bacterial communication
Viruses Lesson Overview Nutrition and Metabolism: Energy Capture
Viruses Lesson Overview Growth, Reproduction, and Recombination Reproduction: binary fission asexual form of reproduction When conditions are favorable, prokaryotes can grow and divide as often as once every 20 minutes! When growth conditions become unfavorable, many prokaryotic cells form an endospore. Endospores can remain dormant for months or even years. The bacterium Bacillus anthracis, which causes the disease anthrax, is one such bacterium.
Viruses Lesson Overview Conjugation conjugation: exchange genetic information bridge forms between two bacterial cells, genetic material, usually in the form of a plasmid, moves from one cell to the other. This transfer of genetic information increases genetic diversity Many plasmids carry genes that enable bacteria to survive in new environments or to resist antibiotics that might otherwise prove fatal.
Viruses Lesson Overview Decomposers Bacteria called actinomycetes are present in soil and in rotting plant material such as fallen logs, where they decompose complex organic molecules into simpler molecules. Bacterial decomposers are also essential to industrial sewage treatment, helping to produce purified water and chemicals that can be used as fertilizers.
Viruses Lesson Overview Producers Cyanobacteria in the genus Anabaena form filamentous chains in ponds and other aquatic environments, where they perform photosynthesis. Photosynthetic prokaryotes are among the most important producers on the planet.
Viruses Lesson Overview Nitrogen Fixers Some plants have symbiotic relationships with nitrogen-fixing prokaryotes. The bacterium Rhizobium grows in nodules, or knobs, on the roots of legume plants such as soybean. The Rhizobium bacteria within these nodules convert nitrogen in the air into the nitrogen compounds essential for plant growth.
Viruses Lesson Overview Human Uses of Prokaryotes, esp. bacteria, are used in the production of many foods and commercial products. Yogurt is produced by the bacterium Lactobacillus. Some bacteria can digest petroleum and remove human-made waste products and poisons from water. Other bacteria are used to synthesize drugs and chemicals through the techniques of genetic engineering. Some adapted to extreme environments may be a rich source of heat-stable enzymes that can be used in medicine, food production, and industrial chemistry.
Viruses Lesson Overview BIOREMEDIATION Bioremediation: use biological organisms to solve an environmental problem To clean up oil spills, bacteria are introduced to the area of the spill where they break down the hydrocarbons of the oil into carbon dioxide Toxic metals, such as mercury , can be converted into nontoxic forms by bacteria